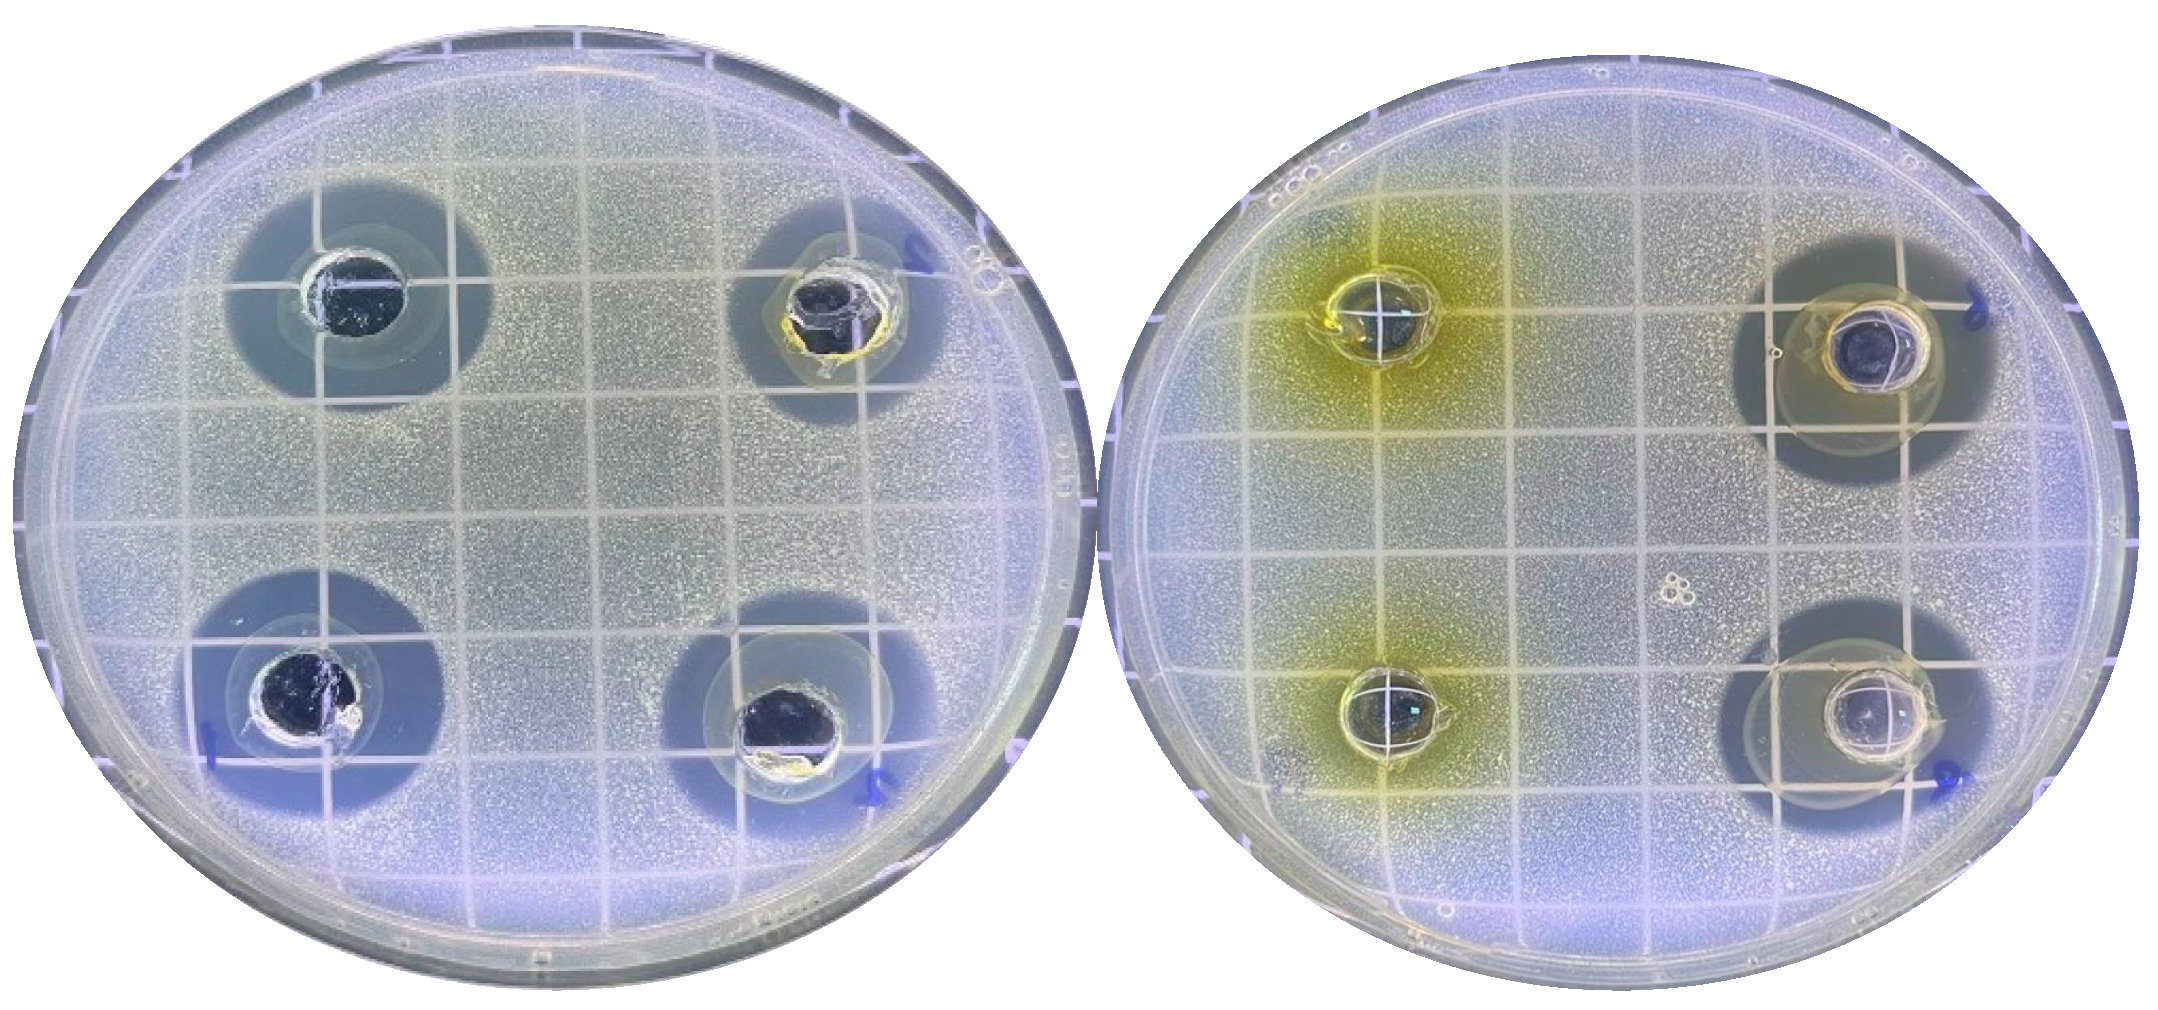
Applsci 14 08305 g002 Applsci 14 08305 g002

Physicochemical, Antimicrobial Properties and Mineral Content of Several Commercially Available Honey Samples
Abstract
1. Introduction
2. Materials and Methods
2.1. Honey Samples
2.2. Chemicals
2.3. Melissopalynological Analysis
2.4. Physicochemical Analyses
2.5. Mineral Content
2.6. Antibacterial Activity
2.7. Statistical Analysis
3. Results and Discussion
3.1. Melissopalynological Analysis
3.2. Physicochemical Characteristics
3.3. Mineral Content
3.4. Antibacterial Activity
3.4.1. Inhibition Zones of Honey Extracts against Different Microorganisms
3.4.2. Minimum Inhibitory Concentration (MIC) of Honey Extracts against Different Microorganisms
3.5. Statistical Analysis
4. Conclusions
Supplementary Materials
Author Contributions
Funding
Institutional Review Board Statement
Informed Consent Statement
Data Availability Statement
Acknowledgments
Conflicts of Interest
References
- Gallego-Picó, A.; Garcinuño-Martínez, R.M.; Fernández-Hernando, P. Honey Authenticity and Traceability. In Comprehensive Analytical Chemistry; Elsevier: Amsterdam, The Netherlands, 2013; pp. 511–541. [Google Scholar]
- Fakhlaei, R.; Selamat, J.; Khatib, A.; Razis, A.F.A.; Sukor, R.; Ahmad, S.; Babadi, A.A. The Toxic Impact of Honey Adulteration: A Review. Foods 2020, 9, 1538. [Google Scholar] [CrossRef]
- Banti, M. Food Adulteration and Some Methods of Detection, Review. Int. J. Nutr. Food Sci. 2020, 9, 86. [Google Scholar] [CrossRef]
- Gustafson, C.R.; Champetier, A.; Tuyizere, O.; Gitungwa, H. The Impact of Honey Fraud Information on the Valuation of Honey Origin: Evidence from an Incentivized Economic Experiment. Food Control 2024, 155, 110070. [Google Scholar] [CrossRef]
- Mureșan, C.I.; Cornea-Cipcigan, M.; Suharoschi, R.; Erler, S.; Mărgăoan, R. Honey Botanical Origin and Honey-Specific Protein Pattern: Characterization of Some European Honeys. LWT 2022, 154, 112883. [Google Scholar] [CrossRef]
- Bodor, Z.; Kovacs, Z.; Benedek, C.; Hitka, G.; Behling, H. Origin Identification of Hungarian Honey Using Melissopalynology, Physicochemical Analysis, and Near Infrared Spectroscopy. Molecules 2021, 26, 7274. [Google Scholar] [CrossRef]
- Puścion-Jakubik, A.; Socha, K.; Borawska, M.H. Comparative Study of Labelled Bee Honey from Poland and the Result of the Melissopalynological Analysis. J. Apic. Res. 2020, 59, 928–938. [Google Scholar] [CrossRef]
- El-Sofany, A.; Al Naggar, Y.; Naiem, E.; Giesy, J.P.; Seif, A. Authentication of the Botanical and Geographic Origin of Egyptian Honey Using Pollen Analysis Methods. J. Apic. Res. 2020, 59, 946–955. [Google Scholar] [CrossRef]
- Mădaş, M.N.; Mărghitaş, L.A.; Dezmirean, D.S.; Bobiş, O.; Abbas, O.; Danthine, S.; Francis, F.; Haubruge, E.; Nguyen, B.K. Labeling Regulations and Quality Control of Honey Origin: A Review. Food Rev. Int. 2020, 36, 215–240. [Google Scholar] [CrossRef]
- Finlay-Smits, S.; Ryan, A.; de Vries, J.R.; Turner, J. Chasing the Honey Money: Transparency, Trust, and Identity Crafting in the Aotearoa New Zealand Mānuka Honey Sector. J. Rural Stud. 2023, 100, 103004. [Google Scholar] [CrossRef]
- Iglesias, A.; Feás, X.; Rodrigues, S.; Seijas, J.A.; Vázquez-Tato, M.P.; Dias, L.G.; Estevinho, L.M. Comprehensive Study of Honey with Protected Denomination of Origin and Contribution to the Enhancement of Legal Specifications. Molecules 2012, 17, 8561–8577. [Google Scholar] [CrossRef]
- Özkök, A.; Bayram, N.E. Kestane (Castanea sativa) Balı Örneklerinin Botanik Orijinlerinin Doğrulanması ve Toplam Polen Sayıları. Uludağ Arıcılık Derg. 2021, 21, 54–65. [Google Scholar] [CrossRef]
- Czipa, N.; Phillips, C.J.C.; Kovács, B. Composition of Acacia Honeys Following Processing, Storage and Adulteration. J. Food Sci. Technol. 2019, 56, 1245–1255. [Google Scholar] [CrossRef]
- Albu, A.; Radu-Rusu, C.-G.; Pop, I.M.; Frunza, G.; Nacu, G. Quality Assessment of Raw Honey Issued from Eastern Romania. Agriculture 2021, 11, 247. [Google Scholar] [CrossRef]
- Brun, F.; Zanchini, R.; Mosso, A.; Di Vita, G. Testing Consumer Propensity towards Novel Optional Quality Terms: An Explorative Assessment of “Mountain” Labelled Honey. AIMS Agric. Food 2020, 5, 190–203. [Google Scholar] [CrossRef]
- Truchado, P.; Ferreres, F.; Bortolotti, L.; Sabatini, A.G.; Tomás-Barberán, F.A. Nectar Flavonol Rhamnosides Are Floral Markers of Acacia (Robinia pseudacacia) Honey. J. Agric. Food Chem. 2008, 56, 8815–8824. [Google Scholar] [CrossRef]
- Louveaux, J.; Maurizio, A.; Vorwohl, G. Methods of Melissopalynology. Bee World 1978, 59, 139–157. [Google Scholar] [CrossRef]
- Bogdanov, S.; Ruoff, K.; Persano Oddo, L. Physicochemical Methods for the Characterisation of Unifloral Honeys: A Review. Apidologie 2004, 35, S4–S17. [Google Scholar] [CrossRef]
- AOAC International. Chapter 44. Sugar and Sugar Products. Subchapter 4. Honey. In Official Methods of Analysis of Association of Analytical Chemists, 19th. ed.; AOAC International: Gaithersburg, MD, USA, 2012; pp. 25–37. [Google Scholar]
- Serin, S.; Turhan, K.N.; Turhan, M. Correlation between Water Activity and Moisture Content of Turkish Flower and Pine Honeys. Food Sci. Technol. 2018, 38, 238–243. [Google Scholar] [CrossRef]
- Ribeiro, R.d.O.R.; Mársico, E.T.; Carneiro, C.d.S.; Monteiro, M.L.G.; Júnior, C.A.C.; Mano, S.; de Jesus, E.F.O. Classification of Brazilian Honeys by Physical and Chemical Analytical Methods and Low Field Nuclear Magnetic Resonance (LF 1H NMR). LWT—Food Sci. Technol. 2014, 55, 90–95. [Google Scholar] [CrossRef]
- Julshamn, K.; Maage, A.; Norli, H.S.; Grobecker, K.H.; Jorhem, L.; Fecher, P. Determination of Arsenic, Cadmium, Mercury, and Lead by Inductively Coupled Plasma/Mass Spectrometry in Foods after Pressure Digestion: NMKL Interlaboratory Study. J. AOAC Int. 2007, 90, 844–856. [Google Scholar] [CrossRef]
- Obey, J.K.; Ngeiywa, M.M.; Lehesvaara, M.; Kauhanen, J.; von Wright, A.; Tikkanen-Kaukanen, C. Antimicrobial Activity of Commercial Organic Honeys against Clinical Isolates of Human Pathogenic Bacteria. Org. Agric. 2022, 12, 267–277. [Google Scholar] [CrossRef]
- Oinaala, D.; Lehesvaara, M.; Lyhs, U.; Tikkanen-Kaukanen, C. Antimicrobial Activity of Organic Honeys against Food Pathogenic Bacterium Clostridium Perfringens. Org. Agric. 2015, 5, 153–159. [Google Scholar] [CrossRef][Green Version]
- Lê, S.; Josse, J.; Husson, F. FactoMineR: An R Package for Multivariate Analysis. J. Stat. Softw. 2008, 25, 1–18. [Google Scholar] [CrossRef]
- Maechler, M.; Rousseeuw, P.; Struyf, A.; Hubert, M.; Hornik, K. R Cluster Package: Cluster Analysis Basics and Extensions. R Package, Version 2.1.6; 2023. Available online: https://cran.r-project.org/web/packages/cluster/index.html (accessed on 1 August 2024).
- Wickham, H.; Chang, W. Ggplot2: An Implementation of the Grammar of Graphics. R Package, Version 3.5.1; 2024. Available online: https://cran.r-project.org/web/packages/ggplot2/index.html (accessed on 1 August 2024).
- Von Der Ohe, W.; Oddo, L.P.; Piana, M.L.; Morlot, M.; Martin, P. Harmonized Methods of Melissopalynology. Apidologie 2004, 35, S18–S25. [Google Scholar] [CrossRef]
- Kurmanov, R. Lime Tree Honey Resources in Eurasia. Grana 2023, 62, 277–290. [Google Scholar] [CrossRef]
- Lazarieva, L.M.; Postoienko, V.O.; Antonenko, P.P.; Merzlova, H.V.; Pushkar, T.D.; Cherniuk, S.V.; Rozputnii, O.I.; Korol, A.P.; Herasymenko, V.Y. Assessment of Acacia Monofloral Honey. Ukr. J. Ecol. 2021, 11, 106–110. [Google Scholar]
- Uršulin-Trstenjak, N.; Puntarić, D.; Levanić, D.; Gvozdić, V.; Pavlek, Ž.; Puntarić, A.; Puntarić, E.; Puntarić, I.; Vidosavljević, D.; Lasić, D.; et al. Pollen, Physicochemical, and Mineral Analysis of Croatian Acacia Honey Samples: Applicability for Identification of Botanical and Geographical Origin. J. Food Qual. 2017, 2017, 1–11. [Google Scholar] [CrossRef]
- Avşar, C.; Aslan, H.; Yumak, T.; Tabak, A.; Deniz, N.T. Determination of the Superior Quality Properties of Randomly Selected Chestnut Honey Samples from the Sinop Region. Spectrosc. Lett. 2023, 56, 353–363. [Google Scholar] [CrossRef]
- Resmî Gazete Turkish Food Codex Honey Communiqué (No: 2020/7). 2020. Available online: https://www.resmigazete.gov.tr/22.04.2020 (accessed on 12 August 2024).
- Cucu, A.-A.; Bobiș, O.; Bonta, V.; Moise, A.R.; Pașca, C.; Cornea-Cipcigan, M.; Mărgăoan, R.; Dezsi, Ș.; Botezan, S.; Baciu, E.-D.; et al. Unraveling the Physicochemical, Nutritional and Antioxidant Properties of the Honey Produced from the Fallopia Japonica Plant. Foods 2024, 13, 1959. [Google Scholar] [CrossRef]
- Escuredo, O.; Silva, L.R.; Valentão, P.; Seijo, M.C.; Andrade, P.B. Assessing Rubus Honey Value: Pollen and Phenolic Compounds Content and Antibacterial Capacity. Food Chem. 2012, 130, 671–678. [Google Scholar] [CrossRef]
- ASRO SR 784-1:2009; Honey. Part 1: Quality Requirements at Delivery by Producers. Romanian Standards Association: Bucharest, Romania, 2009.
- Anupama, D.; Bhat, K.; Sapna, V. Sensory and Physicochemical Properties of Commercial Samples of Honey. Food Res. Int. 2003, 36, 183–191. [Google Scholar] [CrossRef]
- Acquarone, C.; Buera, P.; Elizalde, B. Pattern of PH and Electrical Conductivity upon Honey Dilution as a Complementary Tool for Discriminating Geographical Origin of Honeys. Food Chem. 2007, 101, 695–703. [Google Scholar] [CrossRef]
- Pascual-Maté, A.; Osés, S.M.; Fernández-Muiño, M.A.; Sancho, M.T. Methods of Analysis of Honey. J. Apic. Res. 2018, 57, 38–74. [Google Scholar] [CrossRef]
- Oroian, M.; Paduret, S.; Amariei, S.; Gutt, G. Chemical Composition and Temperature Influence on Honey Texture Properties. J. Food Sci. Technol. 2016, 53, 431–440. [Google Scholar] [CrossRef] [PubMed]
- Solayman, M.; Islam, M.A.; Paul, S.; Ali, Y.; Khalil, M.I.; Alam, N.; Gan, S.H. Physicochemical Properties, Minerals, Trace Elements, and Heavy Metals in Honey of Different Origins: A Comprehensive Review. Compr. Rev. Food Sci. Food Saf. 2016, 15, 219–233. [Google Scholar] [CrossRef]
- Bodó, A.; Radványi, L.; Kőszegi, T.; Csepregi, R.; Nagy, D.U.; Farkas, Á.; Kocsis, M. Quality Evaluation of Light- and Dark-Colored Hungarian Honeys, Focusing on Botanical Origin, Antioxidant Capacity and Mineral Content. Molecules 2021, 26, 2825. [Google Scholar] [CrossRef] [PubMed]
- Kivima, E.; Tanilas, K.; Martverk, K.; Rosenvald, S.; Timberg, L.; Laos, K. The Composition, Physicochemical Properties, Antioxidant Activity, and Sensory Properties of Estonian Honeys. Foods 2021, 10, 511. [Google Scholar] [CrossRef] [PubMed]
- Delmoro, J.; Muñoz, D.; Nadal, V.; Clementz, A.; Pranzetti, V. El Color En Los Alimentos: Determinación de Color En Mieles. Invenio 2010, 13, 145–152. [Google Scholar]
- Živkov Baloš, M.; Popov, N.; Vidaković, S.; Ljubojević Pelić, D.; Pelić, M.; Mihaljev, Ž.; Jakšić, S. Electrical Conductivity and Acidity of Honey. Arch. Vet. Med. 2018, 11, 91–101. [Google Scholar] [CrossRef]
- Kaškonienė, V.; Venskutonis, P.R.; Čeksterytė, V. Carbohydrate Composition and Electrical Conductivity of Different Origin Honeys from Lithuania. LWT—Food Sci. Technol. 2010, 43, 801–807. [Google Scholar] [CrossRef]
- Tabak, A.; Deniz, N.T.; Avşar, C.; Aslan, H.; Yumak, T. Some Physicochemical Properties of Pure and Pollution-Free Sinop Chestnut Honey. Spectrosc. Lett. 2024, 57, 420–427. [Google Scholar] [CrossRef]
- Chen, C. Relationship between Water Activity and Moisture Content in Floral Honey. Foods 2019, 8, 30. [Google Scholar] [CrossRef] [PubMed]
- van Boekel, M.A.J.S. Moisture Content and Water Activity Relations in Honey: A Bayesian Multilevel Meta-Analysis. J. Food Compos. Anal. 2023, 123, 105595. [Google Scholar] [CrossRef]
- Abramovič, H.; Jamnik, M.; Burkan, L.; Kač, M. Water Activity and Water Content in Slovenian Honeys. Food Control 2008, 19, 1086–1090. [Google Scholar] [CrossRef]
- Mondragón-Cortez, P.; Ulloa, J.A.; Rosas-Ulloa, P.; Rodríguez-Rodríguez, R.; Resendiz Vázquez, J.A. Physicochemical Characterization of Honey from the West Region of México. CyTA—J. Food 2013, 11, 7–13. [Google Scholar] [CrossRef]
- Živkov Baloš, M.; Jakšić, S.; Popov, N.; Mihaljev, Ž.; Ljubojević Pelić, D. Comparative Study of Water Content in Honey Produced in Different Years. Arch. Vet. Med. 2019, 12, 43–53. [Google Scholar] [CrossRef]
- Singh, I.; Singh, S. Honey Moisture Reduction and Its Quality. J. Food Sci. Technol. 2018, 55, 3861–3871. [Google Scholar] [CrossRef]
- Gomes, S.; Dias, L.G.; Moreira, L.L.; Rodrigues, P.; Estevinho, L. Physicochemical, Microbiological and Antimicrobial Properties of Commercial Honeys from Portugal. Food Chem. Toxicol. 2010, 48, 544–548. [Google Scholar] [CrossRef]
- Kek, S.P.; Chin, N.L.; Tan, S.W.; Yusof, Y.A.; Chua, L.S. Classification of Honey from Its Bee Origin via Chemical Profiles and Mineral Content. Food Anal. Methods 2017, 10, 19–30. [Google Scholar] [CrossRef]
- Bosancic, B.; Zabic, M.; Mihajlovic, D.; Samardzic, J.; Mirjanic, G. Comparative Study of Toxic Heavy Metal Residues and Other Properties of Honey from Different Environmental Production Systems. Environ. Sci. Pollut. Res. 2020, 27, 38200–38211. [Google Scholar] [CrossRef]
- Sager, M. Major Minerals and Trace Elements in Different Honeys. Bee World 2020, 97, 70–74. [Google Scholar] [CrossRef]
- Margaoan, R.; Papa, G.; Nicolescu, A.; Cornea-Cipcigan, M.; Kösoğlu, M.; Topal, E.; Negri, I. Environmental Pollution Effect on Honey Bees and Their Derived Products: A Comprehensive Analysis. Environ. Sci. Pollut. Res. 2024; online ahead of print. [Google Scholar] [CrossRef]
- Cucu, A.-A.; Pașca, C.; Cucu, A.-B.; Moise, A.R.; Bobiş, O.; Dezsi, Ș.; Blaga Petrean, A.; Dezmirean, D.S. Evaluation of the Main Macro-, Micro- and Trace Elements Found in Fallopia Japonica Plants and Their Traceability in Its Honey: A Case Study from the Northwestern and Western Part of Romania. Plants 2024, 13, 428. [Google Scholar] [CrossRef] [PubMed]
- Martínez-Ballesta, M.C.; Dominguez-Perles, R.; Moreno, D.A.; Muries, B.; Alcaraz-López, C.; Bastías, E.; García-Viguera, C.; Carvajal, M. Minerals in Plant Food: Effect of Agricultural Practices and Role in Human Health. A Review. Agron. Sustain. Dev. 2010, 30, 295–309. [Google Scholar] [CrossRef]
- Mozrzymas, R. Trace Elements in Human Health. In Recent Advances in Trace Elements; Wiley: Hoboken, NJ, USA, 2018; pp. 373–402. [Google Scholar]
- Chasapis, C.T.; Ntoupa, P.-S.A.; Spiliopoulou, C.A.; Stefanidou, M.E. Recent Aspects of the Effects of Zinc on Human Health. Arch. Toxicol. 2020, 94, 1443–1460. [Google Scholar] [CrossRef] [PubMed]
- Piskin, E.; Cianciosi, D.; Gulec, S.; Tomas, M.; Capanoglu, E. Iron Absorption: Factors, Limitations, and Improvement Methods. ACS Omega 2022, 7, 20441–20456. [Google Scholar] [CrossRef]
- Rusu, I.G.; Suharoschi, R.; Vodnar, D.C.; Pop, C.R.; Socaci, S.A.; Vulturar, R.; Istrati, M.; Moroșan, I.; Fărcaș, A.C.; Kerezsi, A.D.; et al. Iron Supplementation Influence on the Gut Microbiota and Probiotic Intake Effect in Iron Deficiency—A Literature-Based Review. Nutrients 2020, 12, 1993. [Google Scholar] [CrossRef]
- Kuś, P.M.; Szweda, P.; Jerković, I.; Tuberoso, C.I.G. Activity of Polish Unifloral Honeys against Pathogenic Bacteria and Its Correlation with Colour, Phenolic Content, Antioxidant Capacity and Other Parameters. Lett. Appl. Microbiol. 2016, 62, 269–276. [Google Scholar] [CrossRef]
- Cucu, A.-A.; Urcan, A.C.; Bobiș, O.; Bonta, V.; Cornea-Cipcigan, M.; Moise, A.R.; Dezsi, Ș.; Pașca, C.; Baci, G.-M.; Dezmirean, D.S. Preliminary Identification and Quantification of Individual Polyphenols in Fallopia Japonica Plants and Honey and Their Influence on Antimicrobial and Antibiofilm Activities. Plants 2024, 13, 1883. [Google Scholar] [CrossRef]
- Voidarou, C.; Alexopoulos, A.; Plessas, S.; Karapanou, A.; Mantzourani, I.; Stavropoulou, E.; Fotou, K.; Tzora, A.; Skoufos, I.; Bezirtzoglou, E. Antibacterial Activity of Different Honeys against Pathogenic Bacteria. Anaerobe 2011, 17, 375–379. [Google Scholar] [CrossRef]
- Ronsisvalle, S.; Lissandrello, E.; Fuochi, V.; Petronio Petronio, G.; Straquadanio, C.; Crascì, L.; Panico, A.; Milito, M.; Cova, A.M.; Tempera, G.; et al. Antioxidant and Antimicrobial Properties of Casteanea sativa Miller Chestnut Honey Produced on Mount Etna (Sicily). Nat. Prod. Res. 2019, 33, 843–850. [Google Scholar] [CrossRef]
- González-Miret, M.L.; Terrab, A.; Hernanz, D.; Fernández-Recamales, M.Á.; Heredia, F.J. Multivariate Correlation between Color and Mineral Composition of Honeys and by Their Botanical Origin. J. Agric. Food Chem. 2005, 53, 2574–2580. [Google Scholar] [CrossRef]
- Ramly, N.S.; Sujanto, I.S.R.; Tang, J.Y.H.; Abd Ghani, A.; Alias, N.; Bakar, M.F.A.; Ngah, N. Correlation Between the Color Lightness and Sweetness of Stingless Bee Honey with Its Minerals Content. J. Agrobiotechnol. 2021, 12, 88–96. [Google Scholar] [CrossRef]

| ID | Code | Label Information and Botanical Origin | Honey Type | Country of Origin | |
|---|---|---|---|---|---|
| H1 | B1 | Linden, Organic honey | Tilia tomentosa | Flower | Bulgaria |
| H2 | B3 | Mixture | Polyfloral | Flower | Bulgarian |
| H3 | B2 | Acacia | Robinia pseudoacacia | Flower | Bulgarian |
| H4 | K2 | Mountain | Mountain honey | Flower | Cyprus |
| H5 | K1 | Citrus | Citrus limon | Flower | Cyprus |
| H6 | R1 | Raspberry | Rubus idaeus | Flower | Romania |
| H7 | R2 | Knotweed | Fallopia aubertii | Flower | Romania |
| H8 | R3 | Linden | Tilia tomentosa | Flower | Romania |
| H9 | R4 | Oak, Honeydew honey | Quercus robur | Secretion | Romania |
| H10 | 4296 | Thyme | Thymus sp. | Flower | Türkiye |
| H11 | 7480 | Linden | Tilia sp. | Flower | Türkiye |
| H12 | 1374 | Linden | Tilia sp. | Flower | Türkiye |
| H13 | 7694 | Chestnut | Castanea sativa | Flower | Türkiye |
| H14 | 19701-1149 | Chestnut | Castanea sativa | Flower | Türkiye |
| H15 | 6326 | Chestnut | Castanea sativa | Flower | Türkiye |
| H16 | 1373 | Chestnut | Castanea sativa | Flower | Türkiye |
| H17 | 3184 | Chestnut | Castanea sativa | Flower | Türkiye |
| H18 | T1 | Oak, Honeydew honey | Quercus sp. | Secretion | Türkiye |
| ID | Declared Honey Type | Actual Pollen Identified Confirming the Sample Labels (%) | Other Types of Pollen Identified in the Samples |
|---|---|---|---|
| H1 | Linden, Organic | Malvaceae: Tilia spp. 83.65% | Astragalus, Asteraceae, Apiaceae, Fabaceae, Robinia pseudoacacia |
| H2 | Mixture | Brassicaceae: Brassica 20%, Asteraceae 20%, Rosaceae 15%, Fabaceae 10%, Apiaceae 2% | |
| H3 | Acacia | Fabaceae: Robinia pseudoacacia 21.0% | Rosaceae, Apiaceae, Brassicaceae, Lamiaceae |
| H4 | Mountain Honey | Brassicaceae: Brassica sp. 15%, Fabaceae 25%, Rosaceae 5%, Asteraceae 8%, Lamiaceae 10%, Plantaginaceae 2%, Linaceae 1%, Apiaceae 4%, Solanaceae 2%, Scrophulariaceae: Verbascum phlomoides 3% | |
| H5 | Citrus | Rutaceae: Citrus 57.60% | |
| H6 | Raspberry | Rosaceae: Rubus idaeus 26% | |
| H7 | Knotweed | Poligonaceae: Fallopia sp. 13.86% | Tiliaceae, Asteraceae |
| H8 | Linden | Malvaceae: Tilia sp. 2.10% | |
| H9 | Oak Honey (Honeydew) | Fagaceae: Quercus sp. | |
| H10 | Thyme | Lamiaceae: Thymus sp. 8.10% | |
| H11 | Linden | Malvaceae: Tilia 5.40% | |
| H12 | Linden | Malvaceae: Tilia 5.10% | |
| H13 | Chestnut | Fagaceae: Castanea sativa 81.80% | |
| H14 | Chestnut | Fagaceae: Castanea sativa 75.30% | |
| H15 | Chestnut | Fagaceae: Castanea sativa 81.30% | |
| H16 | Chestnut | Fagaceae: Castanea sativa 79.10% | |
| H17 | Chestnut | Fagaceae: Castanea sativa 71.40% | |
| H18 | Oak Honey (Honeydew) | Fagaceae: Quercus sp. |
| ID | pH | Brix | L* | a* | b* | H° | EC (μS/cm) | Water Activity | Moisture Content |
|---|---|---|---|---|---|---|---|---|---|
| H1 | 5.12 ± 0.15 a | 80.93 ± 0.19 a | 92.9 ± 5.43 a | −3.01 ± 0.03 d | 45.42 ± 0.04 c | −86.21 ± 0.02 d | 616.3 ± 5.4 c | 0.5672 ± 0.01 a | 17.5 ± 0.21 a |
| H2 | 4.07 ± 0.26 b | 82.29 ± 0.05 a | 95.83 ± 3.89 a | −1.62 ± 0.01 d | 21.55 ± 0.02 d | −85.71 ± 0.06 d | 443.28 ± 0.99 d | 0.5679 ± 0.00 a | 17.5 ± 0.61 a |
| H3 | 4.28 ± 0.11 b | 80.74 ± 0.02 b | 86.12 ± 5.23 a | 6.53 ± 0.05 bc | 82.3 ± 0.04 a | 85.46 ± 0.00 a | 118.48 ± 0.17 f | 0.5389 ± 0.05 a | 16.0 ± 0.81 b |
| H4 | 4.08 ± 0.10 b | 81.31 ± 0.07 a | 81.12 ± 2.03 a | 8.69 ± 0.01 b | 68.61 ± 0.05 b | 82.79 ± 0.04 a | 419.4 ± 0.14 d | 0.5591 ± 0.01 a | 17.0 ± 0.55 ab |
| H5 | 3.31 ± 0.13 c | 81.99 ± 0.03 a | 74.95 ± 8.02 b | 1.68 ± 0.04 c | 39.17 ± 0.04 c | 87.54 ± 0.05 a | 262.53 ± 0.11 e | 0.5455 ± 0.07 a | 16.2 ± 0.62 b |
| H6 | 4.55 ± 0.21 ab | 82.51 ± 0.03 a | 81.85 ± 4.56 a | 7.93 ± 0.01 b | 72.21 ± 0.08 ab | 83.74 ± 0.03 a | 703.25 ± 1.37 c | 0.5588 ± 0.01 a | 15.6 ± 0.98 b |
| H7 | 4.09 ± 0.05 c | 80.86 ± 0.02 b | 25.72 ± 2.85 d | 31.22 ± 0.41 a | 44.09 ± 0.07 c | 54.7 ± 0.02 c | 654.48 ± 2.1 c | 0.5779 ± 0.01 a | 17.2 ± 0.28 ab |
| H8 | 4.51 ± 0.07 b | 81.21 ± 0.02 b | 91.04 ± 3.31 a | 0.02 ± 0.00 c | 58.85 ± 0.02 b | 89.98 ± 0.00 a | 490.9 ± 0.76 d | 0.5669 ± 0.03 a | 17.0 ± 0.45 ab |
| H9 | 4.84 ± 0.03 ab | 83.45 ± 0.17 a | 80.64 ± 6.51 b | 9.36 ± 0.01 b | 76.94 ± 0.01 ab | 83.07 ± 0.04 a | 901.68 ± 4.92 b | 0.5466 ± 0.01 a | 14.6 ± 0.49 b |
| H10 | 4.19 ± 0.03 bc | 82.7 ± 0.04 a | 75.86 ± 4.59 b | 12.55 ± 0.01 b | 68.15 ± 0.03 b | 79.57 ± 0.01 ab | 373.53 ± 0.12 de | 0.5467 ± 0.01 a | 15.6 ± 0.31 b |
| H11 | 4.22 ± 0.01 bc | 81.03 ± 0.01 b | 83.23 ± 5.69 ab | 6.7 ± 0.01 b | 72.17 ± 0.04 ab | 84.7 ± 0.01 a | 428.03 ± 0.29 d | 0.5796 ± 0.04 a | 17.2 ± 0.28 ab |
| H12 | 4.72 ± 0.02 ab | 80.15 ± 0.02 c | 78.65 ± 6.71 b | 12.35 ± 0.06 b | 84.03 ± 0.03 a | 81.64 ± 0.05 a | 855.6 ± 4.52 b | 0.6043 ± 0.02 a | 18.2 ± 0.45 a |
| H13 | 4.59 ± 0.11 ab | 80.13 ± 0.01 c | 56.98 ± 5.42 bc | 37.72 ± 0.51 a | 94.45 ± 0.07 a | 68.23 ± 0.02 b | 1097 ± 5.00 b | 0.5936 ± 0.01 a | 18.1 ± 0.76 a |
| H14 | 4.85 ± 0.20 a | 79.95 ± 0.01 c | 66.51 ± 3.29 b | 23.25 ± 0.08 a | 90.4 ± 0.01 a | 75.58 ± 0.03 ab | 1076 ± 8.90 b | 0.6007 ± 0.02 a | 18.4 ± 0.28 a |
| H15 | 4.47 ± 0.17 ab | 81.32 ± 0.03 b | 66.91 ± 7.18 b | 26.21 ± 0.10 a | 97.73 ± 0.01 a | 74.99 ± 0.07 ab | 949.48 ± 0.95 b | 0.5811 ± 0.01 a | 17.0 ± 0.31 ab |
| H16 | 5.25 ± 0.18 a | 79.98 ± 0.01 c | 68.68 ± 9.54 b | 25.44 ± 0.13 a | 100.05 ± 0.02 a | 75.74 ± 0.01 ab | 1408.25 ± 1.5 a | 0.5962 ± 0.01 a | 18.3 ± 0.49 a |
| H17 | 5.13 ± 0.04 a | 80.86 ± 0.02 b | 16.33 ± 8.87 d | 27.8 ± 0.09 a | 28.14 ± 0.03 cd | 45.35 ± 0.02 c | 651.38 ± 0.26 c | 0.5749 ± 0.01 a | 17.4 ± 0.44 a |
| H18 | 4.91 ± 0.03 a | 81.55 ± 0.01 a | 52.5 ± 6.32 bc | 35.1 ± 0.21 a | 86.16 ± 0.01 a | 67.84 ± 0.01 b | 1452 ± 0.82 a | 0.5932 ± 0.02 a | 16.7 ± 0.32 ab |
| No. | Al | B | Ca | Cr | Cu | Fe | K | Mg | Mn | Na | Ni | P | Zn |
|---|---|---|---|---|---|---|---|---|---|---|---|---|---|
| H1 | 0.41± 0.07 cd | 2.42 ± 0.89 bc | 47.26 ± 7.83 f | 0.02 ± 0.02 a | 0.11 ± 0.06 c | 0.14 ± 0.12 d | 1502.5 ± 340.12 cd | 18.46 ± 3.61 d | 0.4 ± 0.1 d | 119.23 ± 97.97 b | ND | 52.84 ± 13.25 e | ND |
| H2 | 0.51 ± 0.01 cd | 1.54 ± 0.19 c | 23.93 ± 5.13 g | 0.03 ± 0.01 a | 0.02 ± 0.00 c | 0.42 ± 0.03 cd | 132.7 ± 1.98 g | 6.33 ± 0.57 e | 0.04 ± 0.0 e | 2.07 ± 0.03 f | 0.04 ± 0.01 c | 31.07 ± 1.3 f | ND |
| H3 | 0.58 ± 0.13 cd | 4.97 ± 0.24 a | 112.3 ± 4.81 bc | 0.01 ± 0.01 a | 0.16 ± 0.07 bc | 0.78 ± 0.2 cd | 830.15 ± 61.59 f | 24.91 ± 1.1 d | 0.59 ± 0.0 d | 62.99 ± 33.81 d | 0.07 ± 0.01 c | 79.97 ± 10.93 d | ND |
| H4 | 0.9 ± 0.04 c | 3.34 ± 0.03 b | 63.98 ± 7.35 e | ND | 0.09 ± 0.01 c | 0.94 ± 0.1 c | 610.1 ± 11.88 f | 15.79 ± 1.12 de | 0.2 ± 0.01 e | 26.03 ± 5.24 e | ND | 59.34 ± 3.9 de | ND |
| H5 | 0.54 ± 0.1 cd | 3.91 ± 0.1 a | 54.24 ± 0.72 ef | 0.02 ± 0.02 a | 0.08 ± 0.00 | 0.97 ± 0.14 c | 309.1 ± 11.6 g | 12.5 ± 0.15 e | 0.12 ± 0.0 e | 19.51 ± 3.47 e | ND | 55.65 ± 10.61 de | ND |
| H6 | 5.7 ± 0.02 b | 4.07 ± 0.16 a | 50.58 ± 12.66 ef | 0.02 ± 0.01 a | 0.46 ± 0.01 a | 1.44 ± 0.09 b | 1368 ± 42.43 d | 59.57 ± 2.68 b | 5.88 ± 0.04 b | ND | 0.35 ± 0.02 b | 150 ± 6.65 b | ND |
| H7 | 0.6 ± 0.04 cd | 6.15 ± 0.19 a | 119.3 ± 0.14 b | 0.03 ± 0.01 a | 0.29 ± 0.00 b | 1.24 ± 0.2 bc | 1009.25 ± 46.32 e | 50.93 ± 2.06 b | 0.59 ± 0.02 d | 5.59 ± 7.91 f | 0.09 ± 0.00 c | 144.7 ± 15.7 b | ND |
| H8 | 0.28 ± 0.18 d | 2.79 ± 0.88 bc | 119.39 ± 27.45 b | 0.02 ± 0.00 a | 0.06 ± 0.00 c | 0.78 ± 1.07 cd | 1247.9 ± 391.88 d | 46.74 ± 8.76 b | 0.35 ± 0.03 d | 158.7 ± 32.95 b | 0.03 ± 0.02 c | 134.3 ± 35.21 bc | ND |
| H9 | 4.03 ± 0.04 b | 3.53 ± 0.21 b | 35.41 ± 2.52 fg | 0.03 ± 0.00 a | 0.65 ± 0.02 a | 1.56 ± 0.06 b | 1961 ± 45.25 b | 68.33 ± 4.05 b | 5.04 ± 0.07 b | 76 ± 23.33 c | 0.73 ± 0.03 a | 187.25 ± 24.68 b | 0.18 ± 0.26 b |
| H10 | 0.62 ± 0.13 cd | 2.35 ± 0.01 bc | 84.7 ± 16.91 d | 0.05 ± 0.02 a | 0.18 ± 0.02 b | 1.16 ± 0.1 b | 707.75 ± 127.21 f | 21.86 ± 4.36 d | 0.16 ± 0.02 e | 109.36 ± 20.56 bc | 0.02 ± 0.02 c | 138 ± 18.81 bc | 0.49 ± 0.17 b |
| H11 | 0.99 ± 0.01 c | 2.11 ± 0.00 c | 76.57 ± 3.0 d | 0.02 ± 0.02 a | 0.12 ± 0.01 bc | 1.6 ± 0.13 b | 772.6 ± 22.49 f | 18.98 ± 0.04 d | 0.45 ± 0.03 d | 83.97 ± 2.55 c | 0.02 ± 0.0 c | 126 ± 5.66 bc | ND |
| H12 | 1.7 ± 0.14 c | 1.61 ± 0.03 c | 93.84 ± 2.84 c | 0.03 ± 0.03 a | 0.23 ± 0.01 b | 1.54 ± 0.03 b | 1906 ± 84.85 c | 36.83 ± 1.16 c | 1.3 ± 0.01 c | 100.48 ± 3.85 bc | 0.03 ± 0.01 c | 154.1 ± 2.12 b | ND |
| H13 | 1.39 ± 0.04 c | 1.12 ± 0.17 cd | 165.95 ± 6.43 b | 0.02 ± 0.02 a | 0.2 ± 0.02 b | 1.32 ± 0.08 b | 2193.5 ± 26.16 b | 42.29 ± 0.51 bc | 4.86 ± 0.09 b | 84.67 ± 16.1 c | ND | 117.5 ± 18.24 c | ND |
| H14 | 2.52 ± 0.12 c | 2.17 ± 0.07 c | 121.85 ± 3.89 b | 0.02 ± 0.01 a | 0.39 ± 0.03 ab | 3.27 ± 0.05 a | 2328.5 ± 57.28 b | 44.69 ± 1.55 b | 2.35 ± 0.04 c | 90.32 ± 2.51 c | 0.06 ± 0.01 c | 159.4 ± 2.55 b | ND |
| H15 | 11.73 ± 0.35 a | 3.4 ± 0.01 b | 133.95 ± 1.48 b | 0.02 ± 0.01 a | 0.42 ± 0.00 a | 2.4 ± 0.05 b | 1968.5 ± 68.59 b | 55.55 ± 0.25 b | 1.61 ± 0.02 c | 96.28 ± 3.61 c | 0.14 ± 0.01 bc | 181.4 ± 4.24 b | ND |
| H16 | 1.1 ± 0.01 c | 0.09 ± 0.05 d | 98.1 ± 15.85 b | 0.01 ± 0.01 a | 0.07 ± 0.01 c | 1.36 ± 0.04 b | 2421 ± 82.02 b | 25.61 ± 3.64 d | 3.1 ± 0.05 bc | 253 ± 15.7 a | ND | 98.68 ± 0.74 c | 1.86 ± 0.35 a |
| H17 | 0.27 ± 0.04 d | ND | 58.37 ± 2.46 e | ND | ND | 0.3 ± 0.02 cd | 964.05 ± 46.32 e | 45.98 ± 1.87 b | 0.03 ± 0.00 e | 311.75 ± 12.66 a | ND | 70.35 ± 0.33 d | ND |
| H18 | 2.09 ± 0.38 c | 2.66 ± 0.03 bc | 104.81 ± 8.05 a | 0.02 ± 0.00 a | 0.76 ± 0.00 a | 2.04 ± 0.09 bc | 3303 ± 72.12 a | 107.3 ± 2.12 a | 8.83 ± 0.03 a | 91.68 ± 31.28 c | 0.11 ± 0.02 bc | 257.1 ± 14.71 a | ND |
| ID | EC | KA | ST | SP | SA | LM |
|---|---|---|---|---|---|---|
| H1 | 11.7 ± 0.7 ab | 10.0 ± 0.0 d | 16.1 ± 0.1 a | 26.8 ± 0.1 a | 21.3 ± 0.4 a | 12.7 ± 0.5 b |
| H2 | 12.2 ± 0.8 ab | 15.5 ± 0.8 a | 15.6 ± 0.2 a | 23.1 ± 1.0 b | 22.3 ± 0.8 a | 15.1 ± 0.3 a |
| H3 | 10.6 ± 0.0 cd | 10.5 ± 0.5 d | 11.6 ± 0.1 c | 17.4 ± 0.5 c | 16.9 ± 0.2 d | 11.5 ± 0.1 b |
| H4 | 10.9 ± 0.4 c | 14.9 ± 1.4 a | 15.6 ± 0.8 a | 21.5 ± 3.2 b | 20.6 ± 1.0 b | 14.5 ± 0.1 a |
| H5 | 9.9 ± 0.3 d | 13.9 ± 0.3 b | 12.8 ± 1.1 c | 18.2 ± 0.6 c | 16.4 ± 0.4 d | 12.6 ± 0.1 b |
| H6 | 10.8 ± 0.1 c | 14.0 ± 0.0 b | 12.5 ± 0.8 c | 15.4 ± 0.4 c | 18.3 ± 1.6 c | 13.6 ± 0.4 ab |
| H7 | 10.7 ± 0.1 c | 12.5 ± 1.8 c | 13.5 ± 1.2 b | 19.6 ± 0.0 bc | 18.9 ± 1.3 bc | 14.9 ± 0.1 a |
| H8 | 10.7 ± 0.3 c | 11.9 ± 0.1 c | 10.2 ± 0.1 c | ND | ND | ND |
| H9 | 11.5 ± 0 b | 13.5 ± 0.8 b | 13.9 ± 0.8 b | 22.0 ± 0.5 b | 22.2 ± 0.9 a | 15.3 ± 0.4 a |
| H10 | 12 ± 0.8 ab | 13.7 ± 1.1 b | 16.1 ± 0 a | 20.5 ± 1.1 b | 11.76 ± 1.3 d | 12.5 ± 0.2 b |
| H11 | 10.5 ± 1.0 cd | 14.4 ± 0.8 ab | 11.9 ± 0.0 c | 11.0 ± 0.1 d | 17.9 ± 0.4 c | ND |
| H12 | 10.8 ± 0.3 c | 14.3 ± 1.9 ab | 13.2 ± 0.1 b | 21.7 ± 0.6 b | 23.2 ± 1.2 a | 13.2 ± 0.2 ab |
| H13 | 10.6 ± 0.2 cd | 13.0 ± 0.8 bc | 11.2 ± 1.6 c | 9.9 ± 0.4 d | 14.2 ± 1.1 d | ND |
| H14 | 10.7 ± 0.6 c | 11.8 ± 1.5 cd | 14.3 ± 1.8 b | 17.9 ± 0.2 c | 18.4 ± 0.0 c | ND |
| H15 | 10.8 ± 0.1 c | 9.6 ± 0.0 d | ND | 19 ± 0.3 c | 20.0 ± 0.5 c | 11.2 ± 0.0 b |
| H16 | 10.9 ± 0.1 c | 10.9 ± 0.3 d | 10.6 ± 0.6 c | ND | 12.8 ± 0.7 d | ND |
| H17 | 10.5 ± 0.1 cd | 9.8 ± 0.1 d | 10.0 ± 0.1 c | ND | ND | ND |
| H18 | 13.9 ± 0.8 a | 13 ± 0.2 bc | 16.2 ± 1.7 a | 22.9 ± 1.6 b | 22.7 ± 0.4 a | 16.3 ± 0.5 a |
Disclaimer/Publisher’s Note: The statements, opinions and data contained in all publications are solely those of the individual author(s) and contributor(s) and not of MDPI and/or the editor(s). MDPI and/or the editor(s) disclaim responsibility for any injury to people or property resulting from any ideas, methods, instructions or products referred to in the content. |
© 2024 by the authors. Licensee MDPI, Basel, Switzerland. This article is an open access article distributed under the terms and conditions of the Creative Commons Attribution (CC BY) license (https://creativecommons.org/licenses/by/4.0/).
Share and Cite
Yaman, K.; Nicolescu, A.; Tepe, O.; Cornea-Cipcigan, M.; Aydoğan-Çoşkun, B.; Mărgăoan, R.; Şenoğul, D.; Topal, E.; Bouari, C.M. Physicochemical, Antimicrobial Properties and Mineral Content of Several Commercially Available Honey Samples. Appl. Sci. 2024, 14, 8305. https://doi.org/10.3390/app14188305
Yaman K, Nicolescu A, Tepe O, Cornea-Cipcigan M, Aydoğan-Çoşkun B, Mărgăoan R, Şenoğul D, Topal E, Bouari CM. Physicochemical, Antimicrobial Properties and Mineral Content of Several Commercially Available Honey Samples. Applied Sciences. 2024; 14(18):8305. https://doi.org/10.3390/app14188305
Chicago/Turabian StyleYaman, Kerem, Alexandru Nicolescu, Onur Tepe, Mihaiela Cornea-Cipcigan, Burcu Aydoğan-Çoşkun, Rodica Mărgăoan, Dilek Şenoğul, Erkan Topal, and Cosmina Maria Bouari. 2024. "Physicochemical, Antimicrobial Properties and Mineral Content of Several Commercially Available Honey Samples" Applied Sciences 14, no. 18: 8305. https://doi.org/10.3390/app14188305
APA StyleYaman, K., Nicolescu, A., Tepe, O., Cornea-Cipcigan, M., Aydoğan-Çoşkun, B., Mărgăoan, R., Şenoğul, D., Topal, E., & Bouari, C. M. (2024). Physicochemical, Antimicrobial Properties and Mineral Content of Several Commercially Available Honey Samples. Applied Sciences, 14(18), 8305. https://doi.org/10.3390/app14188305

